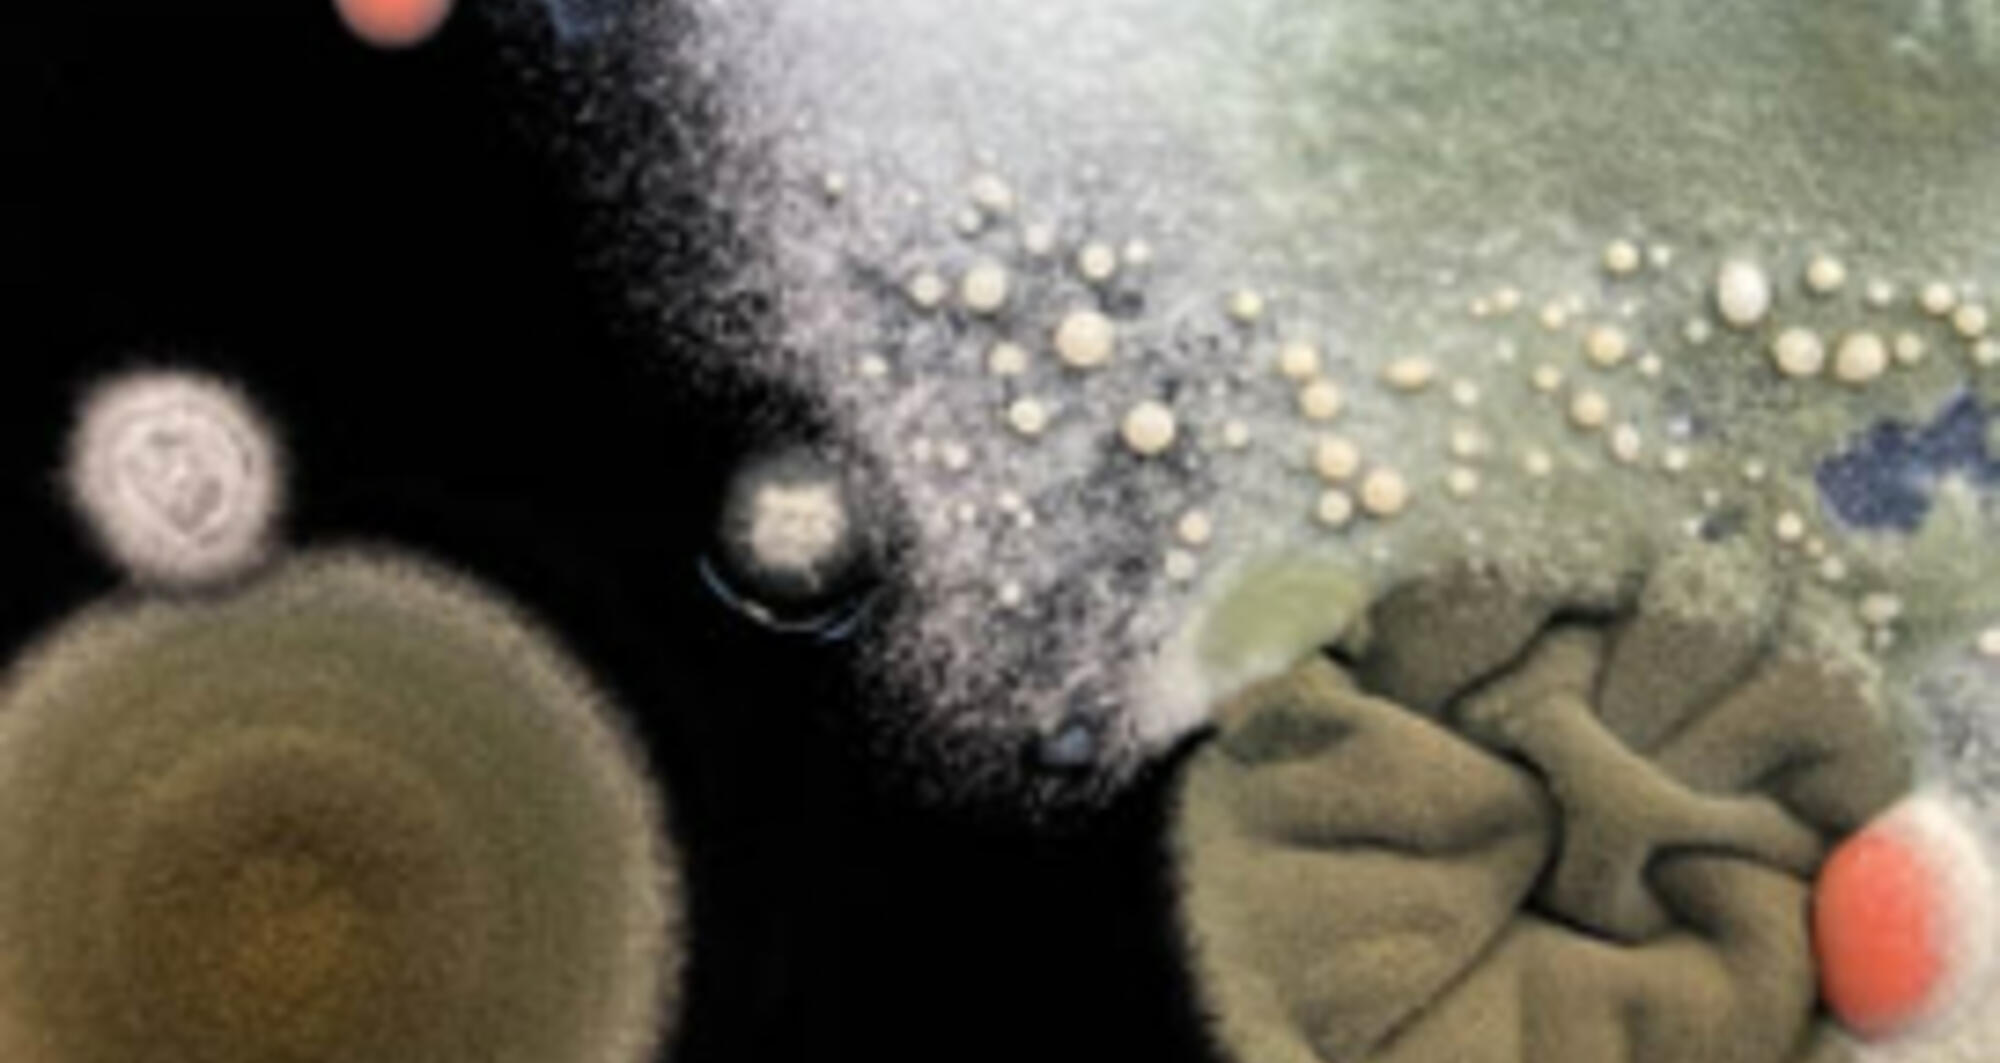
EL PENSAMENT SALVATGE

Show finished
Zip
Five days of new theatre formats
How do we coexist with other species? How is our planet related to the universe? What does a colony of fungi have in common with a landfill site?
Ecology in all its senses is the guiding thread of this first edition of the ZIP Festival. From the smallest to the most universal gesture.
For five days the TNC will become a meeting point of the hybrid theatre panorama with names such as Sociedad Doctor Alonso, Psirc, Elena Córdoba, Rosa Casado and Mike Brookes, Xesca Salvà and Marc Villanueva Mir, Laboratorio de Pensamiento Lúdico and Elisa Martínez & Co.
Exhibitions, meetings and activities
From June 15 to 19: Exhibitions in the different spaces of the TNC. Free entrance.
From June 15 to 19: International youth meetings (YPAL + ESCENA 25) in the different spaces of the TNC.
June 15, 17, 18 and 19: Xerrades a la frescaat the TNC peristyle bar. Free entrance. With the participation of ISEA2022 Barcelona (International Symposium on Electronic Art).
June 17 and 21: Seqüències fantasma d’una fi del món and Maddi Barber. Curtmetratges. Filmoteca de Catalunya.
Shows
Sociedad Doctor Alonso
Sala Gran. Running time: 55 min
15 and 16 June 2022, 8 pm
Price: 8€
Sociedad Doctor Alonso creates an interactive show, a journey to explore our relationship with space.
Focusing on the concept of “Hammam” as a container of an ambiance and a temperature, Hammamturgia captures the flow of bodies and suggests transformations to activate a choreographic piece which dialogues with space and time.
Like the theory of endosymbiosis by Lynn Margulis, who sees the bacterial relationship as a crucial engine of life and adaptation, Sociedad Doctor Alonso researches a symbiotic relationship between creators, spectators, space and the theatre piece to examine how exterior conditions modify the relationships between bodies.
Move through the Sala Gran in a new way. Go up on the stage, enter and walk through, look at the environmental conditions and let things happen. Transform yourself while transforming the piece.
De quan Artemisa i el Leviatà del pantà
De quan Prometeu, els Bitcoins i el Martell de la Mort
Psirc
Sala Gran. Running time: 1 h
18/06/22 at 5 pm and 19/06/22 at 8 pm
Price: 8 €
It is on the fringes where we are allowed to exist and create without norms.
Psirc presents two of the four chapters of the Després de tot to, what explore marginality from a philosophical, political and social viewpoint. By combining music and circus, the company addresses the fragile balance between global ecology and spiritual crisis.
Mythological classical characters and state-of-the-art technology coexist in a borderline place, the outskirts of any civilisation; an endangered landscape that Google probably locates at the ends of the earth. An epic on the everyday life of existences conceived from the fringe.
The unknown engenders fear but also fascination.
Submerge into the swamp.
Rosa Casado and Mike Brookes
Sala Tallers. Running time: 1 h
15 to 19 June 2022, 6.30 pm
Price: 8 €
A delicate and thorough poetic action to connect us with other places and times.
For five days the artists Rosa, Mike and their collaborators will dismantle each and every part of a second-hand car, a meticulous action of separation and classification of the materials that make up the vehicle in order to think about the residual and the material connectivity of distant places. During the course of these five days, five different performances will propose diverse perspectives and a different scale of relation with the world through this object.
Episode 1 [15/06/22] begins with the final journey of one of the 1 billion cars estimated to be currently driving around the streets of the world.
Episode 2 [16/06/22] looks up at the thin layer of atmosphere that surrounds the planet, and at how the things it picks up and blows around us define what we see.
Episode 3 [17/06/22] imagines the human population as a force of nature, and the scale of geological forces and events that might begin to mirror our own.
Episode 4 [18/06/22] follows the dust that
rises and settles from everything we do, and the remnants we all just pass on to our neighbours, and never escape.
Episode 5 [19/06/22] collects everything that we might find a new use or purpose for, tries to give it away, and takes a look at what is left.
Elena Córdoba
Sala Petita. Running time: 1 h 10 min
17 and 18 June 2022, 8 pm
Price: 8 €
Elena Córdoba spent the pandemic looking at microscopic worlds. Vegetal textures augmented under the lens to the extent of losing their reference of origin. Flowers, moss, leaves, lichens…
Y pareceremos árboles combines dance, the study of the anatomy and the projection of these vegetal realities augmented with a microscope to create fictional unions between the body and the forms of organisation of the plants.
The human body is full of vegetal forms: tree-shaped neurones which come together to form forests, small electric trees where our thoughts emerge, branches of the nervous system which look like the most intricate roots...
We are a garden, and Elena Córdoba and her company imagine a future in which their dancer bodies turn green and become trees.
Ficciones botánicas are: David Benito, Ana Botía, Elena Córdoba, Carlos Marquerie, Cecilia Molano, Clara Pampyn, María José Pire, Luz Prado, and Jesús Rubio Gamo.
EL PENSAMENT SALVATGE
Xesca Salvà and Marc Villanueva Mir
Gardens and warehouses.
15 and 19 June 2022
Price: 8 € (Inoculation ritual and Planetary exploration)
1. Inoculation ritual. 15 June 2022, 5 pm. Gardens Sala Tallers. Running time:1 h 30 min
2. Growth period. 16, 17 and 18 June 2022. Paint workshop. Running time: 45 min
3. Planetary exploration. 19 June 2022, 12.30 am Magatzems. Warehouses. Running time: 45 min
A gigantic laboratory dish. Hands full of microbes. And time. These are the three elements needed to create the fungal colony that we will see grow live in this piece by the creators Xesca Salvà and Marc Villanueva.
1. Inoculation ritual
A collective and festive meeting where the company and the audience will come together around a Petri dish of two metres in diameter to perform an inoculation ritual. A conversation about the digestive singularities of fungi, their ability as decomposers and transformers of matter, and the environmental meaning of waste.
2. Growth period
For five days the dish will be preserved in the Paint Workshop (access through the passage between the Sala Tallers and the Sala Gran), in a semi-dark and silent environment, while the inoculated fungi and bacteria grow inside. In this period, the dish can be visited freely and at no cost. Come and have a look!
3. Planetary exploration
It is time to see the result. While discovering what has grown within the Petri dish, a sound intervention with percussion and live electronic music will introduce us to a dialogue between the sounds produced by the fungi and the parallelism with human colonisation and urbanisation.
Laboratorio de pensamiento lúdico
Upper hall. Running time: 3 h
18/06/22 at 11 am
Price: 8 €
A game that activates complicities and where players must relate with non-human species (animals, plants, bacteria, fungi…) to survive.
The game invites us to reflect together on the life and death options of a series of hybrid beings, emerged out of imagined kinships in a context of extreme environmental conditions. Mutations, hybridisations, extinctions… The solutions don’t necessarily have to be friendly and will probably always entail serious consequences.
Game of Kin is a game in constant transformation, which generates multiple narratives depending on the discussions, negotiations and agreements reached by the players in each game.
An event that seeks to change the way we think and sow the seed of a world where we can really survive. Because regeneration is still possible but only if we are capable of imagining it.
Video installation
Elisa Martínez
Main lobby
Ftom 4 pm to 8 pm
FREE ENTRANCE
Today the vehicle is still seen as symbol of masculinity and status.
In this video installation, Elisa Martínez uses the formula “luxury car advertising” and the slogan “The Best or Nothing” by Mercedes Benz to confront advertising and the rise in sales of luxury cars with shopping trolleys full of junk, a new element in the urban landscape of Barcelona.
This piece is unsettling because it highlights our own dehumanisation. When we look at a luxury car or a shopping trolley the person vanishes and we are only capable of seeing the material and what it represents.
Prices
5 single tickets to choose from 5 shows or performances Limited availability. Buy the ZIP Festival Pack now and save up to 37%.General information
Buy now!You can exchange your tickets online, by phone 933 065 720 and at the TNC Ticket Office. And if you change your mind, don't worry, you can change them up to 24 hours before the start of the performance.
Promotion limited. Hurry up and don't run out of your ZIP Pack.
Shows included: Hammamturgia, Després de tot, En un día claro puedes ver para siempre, Y pareceremos árboles. Ficciones Botánicas and El pensament salvatge.

HAMMAMTURGIA

DESPRÉS DE TOT

EN UN DÍA CLARO PUEDES VER PARA SIEMPRE
EL PENSAMENT SALVATGE

Y PARECEREMOS ÁRBOLES. FICCIONES BOTÁNICAS

GAME OF KIN

THE BEST OR NOTHING






